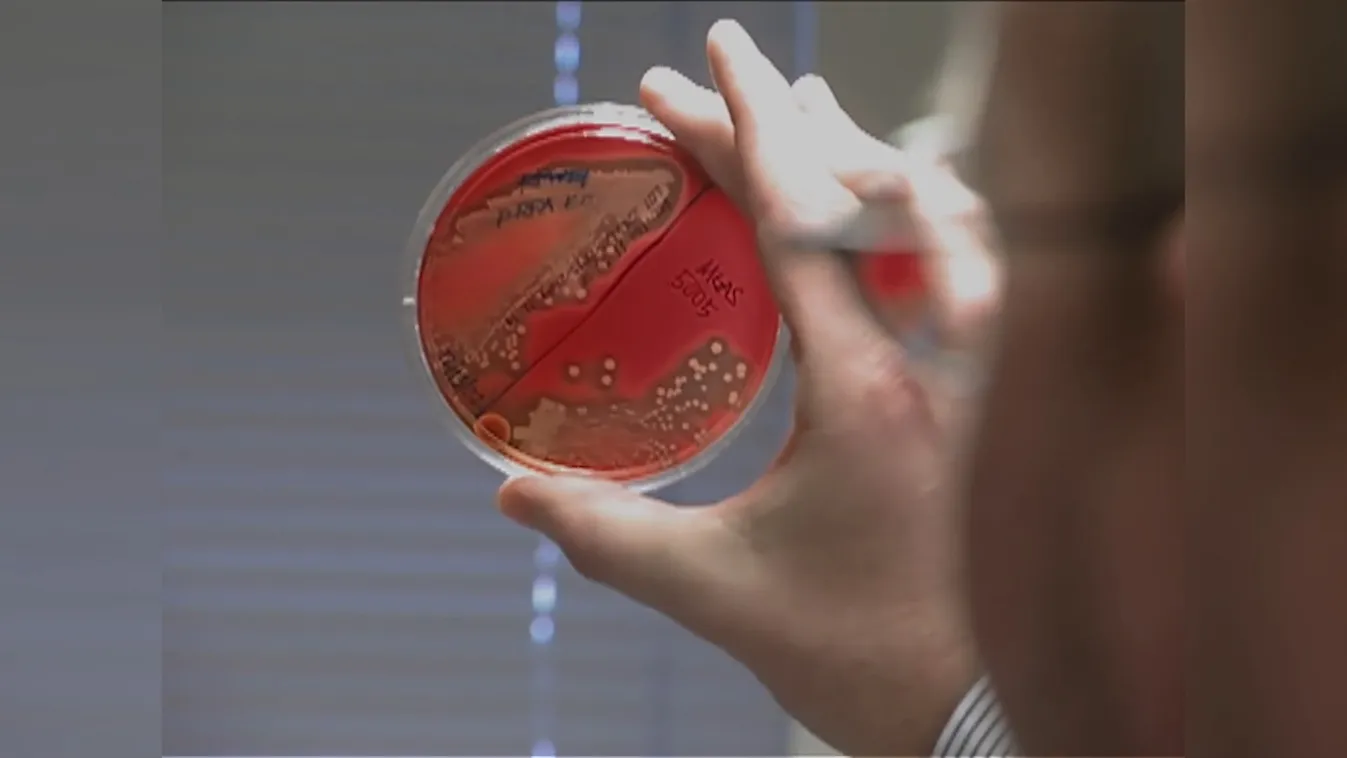
Radar – Egy karcolás is lehet halálos + videó

Keresés
Cikk típusa
Rovatok
Műsor szerint
Dátum tartomány
Rusvai Miklós:
1-10 cikk megjelenítése a(z) 31-ből a keresett kifejezésre


Rusvai Miklós: Magyarország megfelelő átoltottsággal rendelkezik + videó

Radar – Amit tudni erről a nagyon veszélyes, az Ebolához hasonló gyilkos vírusról? + videó

Fertőzésveszélyt jelentenek a vízbe fulladt állatok tetemei + videó

Szalmonella baktériumot mutattak ki a Római-parton + videó
Radar – Egy karcolás is lehet halálos + videó

Egyre nagyobb tempóban terjed a koronavírus új variánsa + videó

Új variánsról beszélt a WHO

Újra növekedhetnek a koronavírusos esetszámok ősztől











